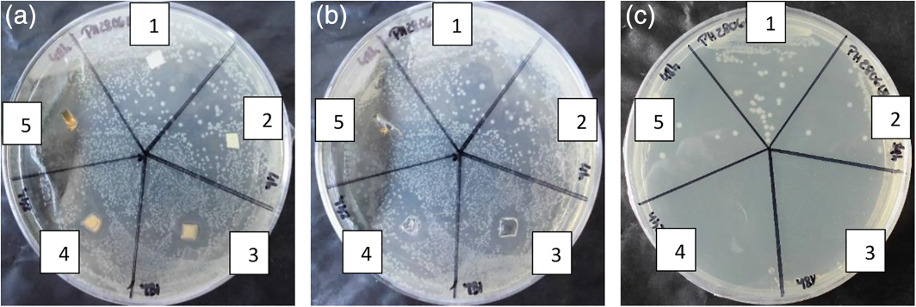

News
Synthesis and properties evaluation of quaternized polyurethanes as antibacterial adhesives
14.01.2019
P. Hu, A. Greiner, S. Agarwal
J. Polym. Sci. Part A: Polym. Chem., 2019, doi:10.1002/pola.29321
We present new side‐chain quaternized polyurethanes as antibacterial adhesives made by polyaddition polymerization followed by quaternization for different time intervals. The degree of quaternization of N‐diol units in the polymer is changed from 13.6 to 99.0 mol % (almost complete) for tuning the antibacterial action (leaching/contact type) and studying effect on adhesive strength. The degree of quaternization of about 26 mol % provided the nonleaching antibacterial effect with adhesive strength more than 60 N cm−2 on aluminum and glass substrates. The increase in the degree of quaternization enhanced polymer polarity shifting nonleaching (contact type) antibacterial behavior to the leaching type but maintaining the high adhesive strengths.